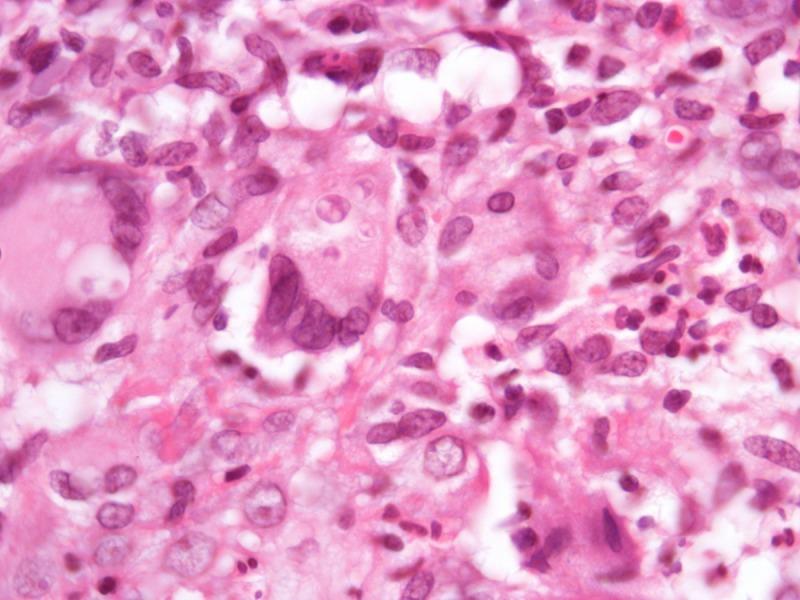
https://cdn.ncbi.nlm.nih.gov/pmc/blobs/9011/3791966/49d4475b4a75/dp0303a05g005a.jpg

Multiple confluent reddish nodules.
作者信息
Jeunon Thiago, de Jesus Barreto Rodrigues Palmira Assis, Rocha Thiara Cristina Guimarães, de Oliveira Bezerra Marina, Galhardo Maria Clara Gutierrez, do Valle Antônio Carlos Francesconi
机构信息
Hospital Federal de Bonsucesso, Rio de Janeiro, Brazil ; ID - Investigação em Dermatologia, Brazil.
出版信息
Dermatol Pract Concept. 2013 Jul 31;3(3):15-20. doi: 10.5826/dpc.0303a05. eCollection 2013.
Abstract
摘要